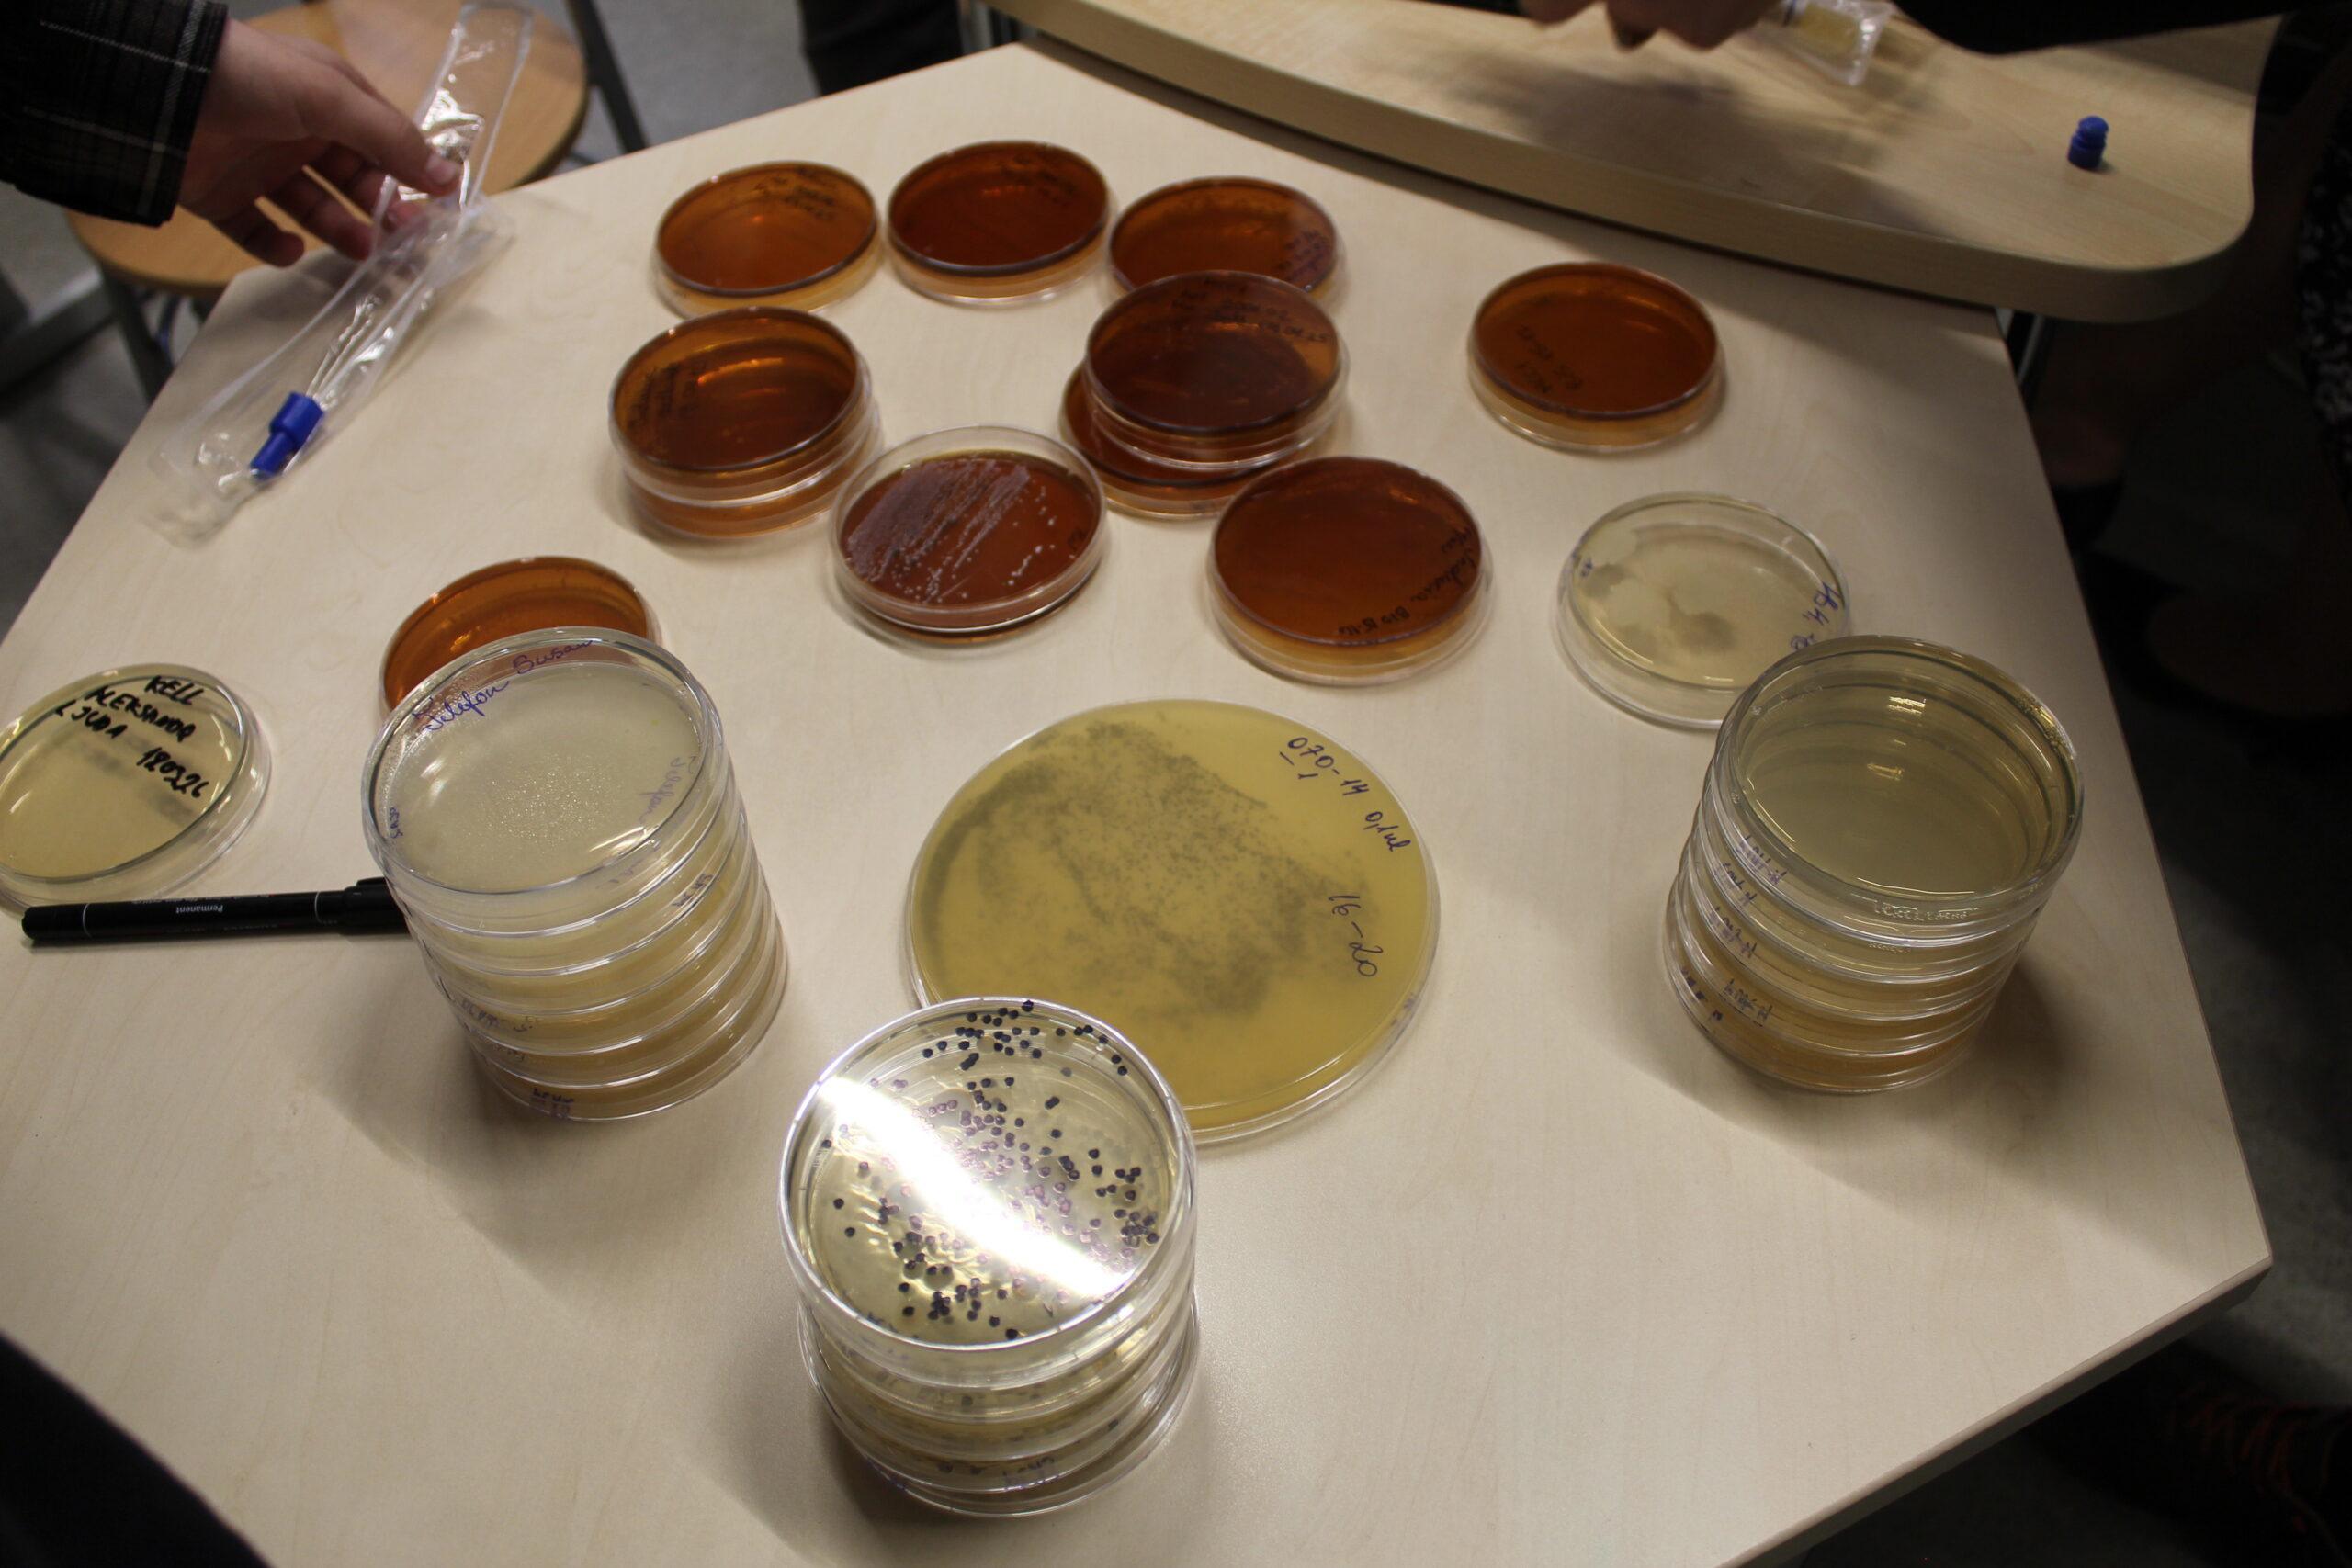

Toidu ja bakterite koostöö
Täna oli meil koolis tõeliselt põnev ja avastusterohke päev! Arenguprogrammi „Koolipere toidutargaks!” raames toimus teadustund teemal “Toidu ja bakterite koostöö”. Teadustund on loodud Tartumaa toidupiirkonna ja teadusarendusettevõte

Playback 2026
18. veebruaril kehastusid meie kooli üheksa õpilast minionideks ning käisid

II trimestri tublimad
Täna tunnustasime II trimestri tublimaid õpilasi. Tunnustasime neid, kes on


Esmaabi koolitus
Tänase tervisepäeva raames toimus õpilastel esmaabi koolitus. Saadi väärtuslikke teadmisi

Toidu ja bakterite koostöö
Täna oli meil koolis tõeliselt põnev ja avastusterohke päev! Arenguprogrammi „Koolipere

Playback 2026
18. veebruaril kehastusid meie kooli üheksa õpilast minionideks ning käisid

II trimestri tublimad
Täna tunnustasime II trimestri tublimaid õpilasi. Tunnustasime neid, kes on



Esmaabi koolitus
Tänase tervisepäeva raames toimus õpilastel esmaabi koolitus. Saadi väärtuslikke teadmisi
Tundide ajad
Tundide ajad
1.–2. tund 8.25–9.50
1. tund 8.25–9.05
2. tund 9.10–9.50
Vahetund 15 minutit
3.–4. tund 10.05–11.30
3. tund 10.05–10.45
4. tund 10.50–11.30
Söögivahetund 30 minutit
5.–6. tund 12.00–13.25
5. tund 12.00–12.40
6. tund 12.45–13.25
Vahetund 10 minutit
7.–8. tund 13.35–15.00
7. tund 13.35–14.15
8. tund 14.20–15.00
Vaheajad
Vaheajad
2024/25. õa
Sügisvaheaeg
21.–27. oktoober 2024
Jõuluvaheaeg
23. detsember 2024 –
5. jaanuar 2025
Talvevaheaeg
24. veebruar –
2. märts 2025
Kevadvaheaeg
11.–20. aprill 2025
Suvevaheaeg
10. juuni –
31. august 2025
Tundide ajad
1. tund – 2. tund
09:00 – 10:20
Lõunasöök (1.–4. klass)
10:20 – 10:50
5.–9. klass: õuevahetund
3. tund
10:50 – 11:30
Lõunasöök (5.–9. klass)
11:30 – 12:00
1.–4. klass: õuevahetund
4. tund
12:00 – 12:40
Vahetund
12:40 – 12:50
5. tund – 6. tund
12:50 – 14:10
OODE
14:10 – 14:20
7. tund
14:20 – 15:00
Vaheajad
2025/26. õa
Sügisvaheaeg
20.–26. oktoober 2025
Jõuluvaheaeg
22. detsember 2025 –
4. jaanuar 2026
Talvevaheaeg
23. veebruar –
1. märts 2026
Kevadvaheaeg
13.–19. aprill 2026
Suvevaheaeg
10. juuni –
31. august 2026